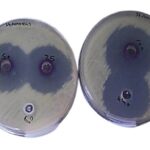
66
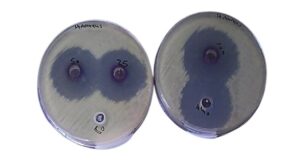
استخلاص وتنقية القلويدات من نبات الاوركيد Phalaenopsis amabilis ودراسة تأثيرها ضد بعض البكتريا المسببة لالتهاب المجاري البولية

نهج هجيني متكامل لتخطيط مسارات الطائرات المسيرة بالتكامل بين تحسين سرب الجسيمات والشبكات العصبية والخوارزمية الجينية وآليات التنعيم الذكي
نهج هجيني متكامل لتخطيط مسارات الطائرات المسيرة بالتكامل بين تحسين سرب الجسيمات والشبكات العصبية والخوارزمية الجينية وآليات التنعيم الذكي
 Geospatial Analysis of the Correlation Between Dust Phenomena Frequency and Surface Wind Speed Using Pearson’s Coefficient and GIS
Geospatial Analysis of the Correlation Between Dust Phenomena Frequency and Surface Wind Speed Using Pearson’s Coefficient and GIS
 Doherty Power Amplifiers in CMOS Technology for 5G Millimetre-Wave Applications: Architectures, Design Techniques, and Performance Trade-offs
Doherty Power Amplifiers in CMOS Technology for 5G Millimetre-Wave Applications: Architectures, Design Techniques, and Performance Trade-offs
استخلاص وتنقية القلويدات من نبات الاوركيد Phalaenopsis amabilis ودراسة تأثيرها ضد بعض البكتريا المسببة لالتهاب المجاري البولية
استخلاص وتنقية القلويدات من نبات الاوركيد Phalaenopsis amabilis ودراسة تأثيرها ضد بعض البكتريا المسببة لالتهاب المجاري البولية
 The Adoption of Hybrid Swarm Intelligence Algorithm in The Optimal Allocation of Physical Cloud Manufacturing Resources
The Adoption of Hybrid Swarm Intelligence Algorithm in The Optimal Allocation of Physical Cloud Manufacturing Resources

هي مجلة علمية محكمة تهدف إلى نشر الأبحاث والمقالات العلمية في مجالات العلوم التطبيقية والصرفة. تركز المجلة على تقديم أحدث الأبحاث والاكتشافات العلمية التي تساهم في تطوير المعرفة العلمية والتكنولوجية


تصريح النشر الورقي والالكتروني من ( ISSN)
اهداف المجلة
نشر البحوث العلمية عالية الجودة
تهدف المجلة إلى نشر الأبحاث والمقالات العلمية ذات الجودة العالية التي تساهم في تطوير المعرفة في مجالات العلوم التطبيقية والصرفة. تسعى المجلة إلى توفير منصة للباحثين لعرض نتائج أبحاثهم واكتشافاتهم العلمية بطريقة مهنية ومحكمة
تعزيز تبادل المعرفة والتعاون العلمي الدولي
تسعى المجلة إلى تعزيز التعاون العلمي بين الباحثين والعلماء من مختلف أنحاء العالم. من خلال نشر الأبحاث من مجموعة متنوعة من التخصصات والدول، تهدف المجلة إلى تسهيل تبادل الأفكار والتجارب العلمية وتشجيع التعاون بين المجتمعات الأكاديمية العالمية
نشر البحوث العلمية عالية الجودة
تهدف المجلة إلى نشر الأبحاث والمقالات العلمية ذات الجودة العالية التي تساهم في تطوير المعرفة في مجالات العلوم التطبيقية والصرفة. تسعى المجلة إلى توفير منصة للباحثين لعرض نتائج أبحاثهم واكتشافاتهم العلمية بطريقة مهنية ومحكمة
شركائنا









قياس نسبة الاستلال
المجلة تستخدم نمودج
المجلة تستخدم نمودج
تصويب اللغة الانكليزي
مجلات أخرى
الإعلانات
معامل التأثير


نصائح قبل ارسال البحوث
- قبل إرسال البحث: فهم المجلة ومتطلباتها
- اقرأ بتمعن: يجب على الباحث قراءة قسم “عن المجلة” و”أهدافها” و”نطاقها” بدقة. هذا يساعده على فهم هل موضوع بحثه يتماشى بالفعل مع توجهات المجلة أم لا.
- تصفح الأعداد السابقة: يجب على الباحث الاطلاع على الأبحاث المنشورة مؤخرًا في المجلة. هذا يمنحه فكرة عن المواضيع التي تُفضلها، ومنهجية الكتابة المعتمدة، وأسلوب التوثيق والمراجع.
- اطلع على شروط النشر: لا يكتفي الباحث بقراءة الأهداف فقط، بل يجب عليه مراجعة “شروط النشر” أو “دليل المؤلفين” الذي يحدد:
- صيغة التوثيق لمجلتنا هي : APA7
- عدد الكلمات المسموح به.
- هيكلية البحث (مقدمة، مشكلة، منهجية، نتائج، خاتمة).
- كيفية إرسال البحث (عبر منصة إلكترونية، أو بالبريد الإلكتروني).
- خلال كتابة البحث: الجودة والمنهجية
- أصالة الموضوع وأهميته: يجب أن يقدم البحث إضافة حقيقية للمعرفة. لا يُكتفى بتكرار أبحاث سابقة، بل يجب أن يطرح مشكلة جديدة، أو منهجية مبتكرة، أو نتائج مختلفة.
- وضوح المنهجية: يجب على الباحث أن يشرح بوضوح المنهجية التي اتبعها (كيف جمع البيانات؟ ما هي أدواته؟ كيف حللها؟)، فوضوح المنهجية يعزز مصداقية البحث.
- سلامة اللغة والتدقيق اللغوي: تُعد الأخطاء اللغوية والإملائية مؤشرًا سلبيًا على جودة البحث. يُنصح الباحث بمراجعة بحثه عدة مرات، ويفضل أن يطلب من زميل أو مدقق لغوي مراجعته قبل الإرسال.
- هيكلية متكاملة: يجب أن يكون البحث منظمًا، من العنوان الواضح والمختصر، إلى المقدمة التي تشرح الإشكالية، ثم المنهجية والنتائج، وصولاً إلى الخاتمة التي تلخص الاستنتاجات وتوصي بمجالات بحثية مستقبلية.
- المراجع الحديثة: يجب أن يعتمد الباحث على أحدث المراجع والدراسات في مجاله، مما يدل على اطلاعه على آخر التطورات العلمية.
- بعد إرسال البحث: الصبر والتجاوب
- الصبر: عملية التحكيم تستغرق وقتًا. يجب على الباحث أن يتحلى بالصبر ويتجنب إرسال استفسارات متكررة قبل انقضاء المدة المحددة للتحكيم.
- التجاوب مع الملاحظات: في حال تلقي الباحث ملاحظات من المحكمين، يجب أن يتعامل معها بجدية وموضوعية. يُطلب منه عادةً تقديم رد مفصل يوضح فيه كيف أخذ بهذه الملاحظات أو يبرر سبب عدم أخذها.
- تحميل قالب الكتابة الخاص بالمجلة بالضغط على : تحميل قالب الكتابة باللغة العربية أو تحميل قالب الكتابة باللغة الإنجليزية
- info@aiajaps.us :ارسال البحث الى الإيميل
- بعد ذلك يتم إبلاغ الباحث بوصول البحث وقبوله بشكل مبدئي بعد الإطلاع عليه للتحقق من اتباع الشروط المطلوبة للنشر وذلك خلال 48 ساعة من وصول البحث لإدارة تحرير المجلة
- يقوم الباحث بدفع رسوم النشر وإرسال إيصال التحويل أو الحوالة المصرفية على البريد الألكتروني للمجلة
- تحرير إفادة قبول أو رفض البحث بالنشر من قبل رئيس تحرير المجلة المجلة
- يحصل الباحث بعد الانتهاء من عملية التحكيم على خطاب مطبوع ومصدق عليه ومعتمد من إدارة المجلة يفيد بقبول نشر البحث ، ويحصل الباحث على نسخة إلكترونية من عدد المجلة الذي نشر فيها بحثه